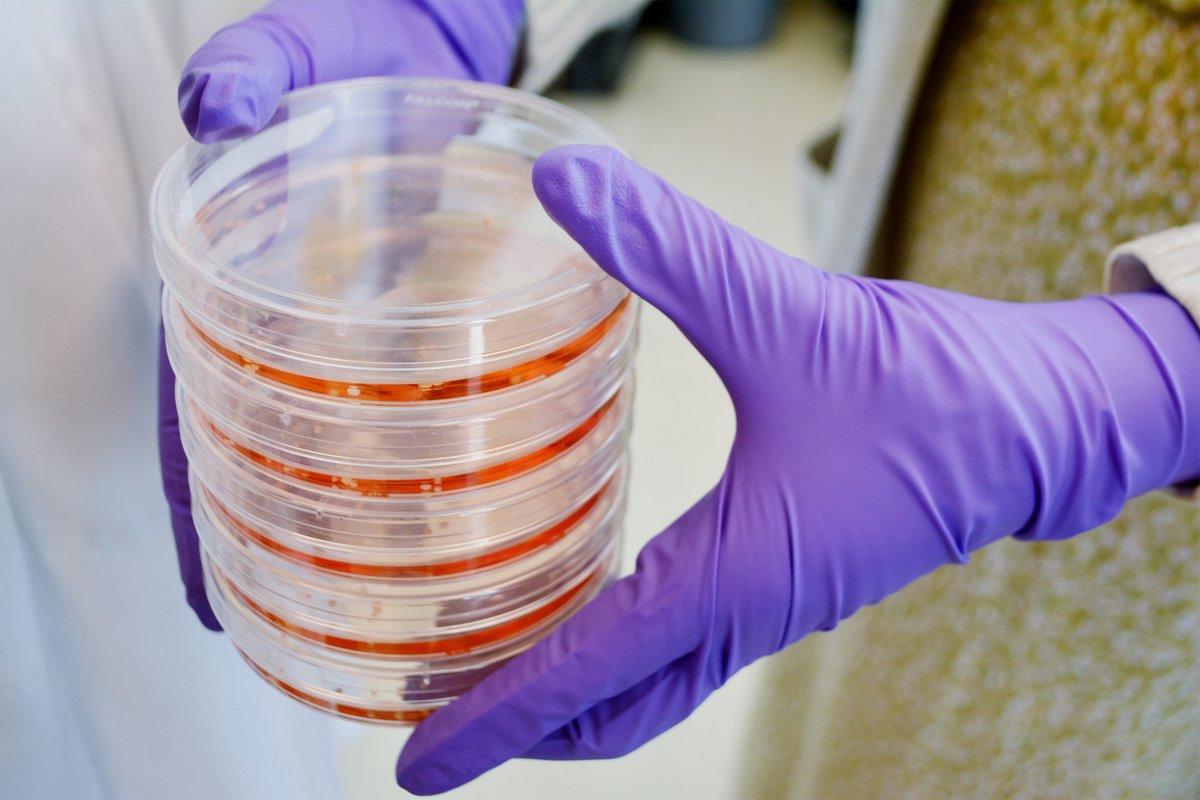
STEMCELL Technologies tweet media

Sabitlenmiş Tweet

We are looking to hire a postdoc! Opportunities to use innovative techniques to address fundamental questions about neuron-glial interactions in the developing brain. Candidates from broad scientific backgrounds encouraged to join our team! Please RT 😀 sloanlab.org

English